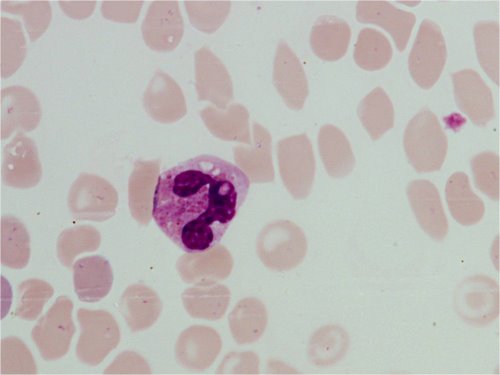
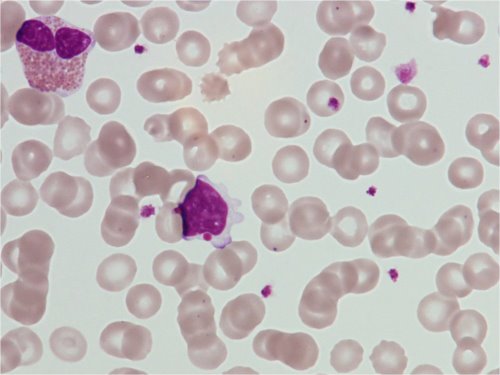
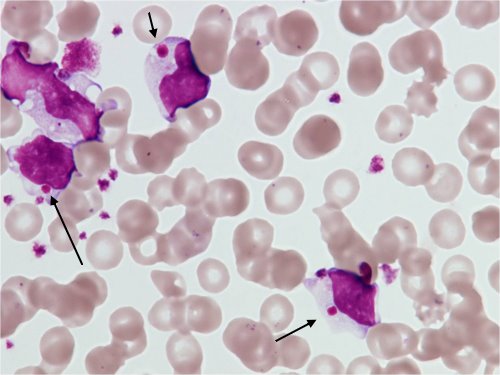
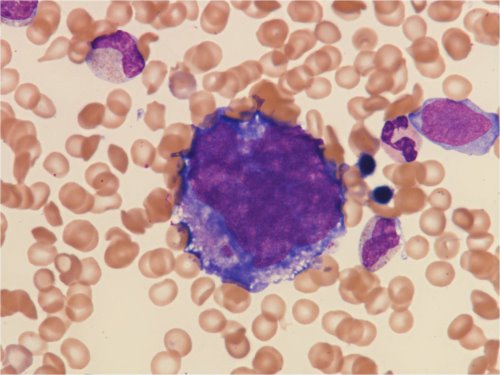

Lasten ei-maligneja veritauteja
Kuvatietokanta
12.6.2012 • Uusi artikkeli
Työryhmä: Ulla Pihkala,
Pasi Huttunen, Minna Koskenvuo, Virve Pentikäinen, Samppa Ryhänen
- Kaikki solulinjat
- Punasolulinjan tauteja
- Kongenitaalinen dyserytropoieettinen anemia (tyyppi II, HEMPAS)
- Valkosolulinjan tauteja
- Chediak–Higashin syndrooma
- Trombosyyttilinjan tauteja
- Akuutti ITP (idiopaattinen trombosytopeeninen purppura)
- Essentielli trombosytemia
Aplastinen anemia
- Kohtalaisen harvinainen lapsilla
- Luuytimen kaikki linjat (erytropoieesi, myelopoieesi, trombopoieesi) ovat hypoplastisia tai aplastisia.
- Perifeerisessä veressä normosytäärinen anemia, leukopenia ja trombopenia
Kongenitaalinen dyserytropoieettinen anemia tyyppi II, HEMPAS
- HEMPAS = hereditary erythroblastic multinuclearity with positive acid serum test
- Perinnöllinen (autosomissa, resessiivinen), erittäin harvinainen
- Normosytäärinen tai makrosytäärinen anemia
- Ineffektiivinen erytropoieesi/dyserytropoieesi
- Luuytimessä runsas erytropoieesi, kaksitumaisia erytroblasteja
- Voi liittyä vaihtelevaa ikterusta, hepatosplemomegaliaa, raudan kertymistä
- HEMPAS: punasolut hajoavat asidifioidussa seerumissa (acid serum test, Ham test).
Chediak–Higashin syndrooma
- Erittäin harvinainen perinnöllinen veritauti; useita tapauksia kuvattu Pohjois-Suomesta
- Defekti granuloiden morfogeneesissä, CHS1-geenin mutaatio; esiintyy kaikissa kudoksissa
- Myelooisessa sarjassa (granulosyytit, monosyytit) ja lymfosyyteissä jättigranuloita/inkluusioita
- Viallinen degranulaatio ja kemotaksis
- Ineffektiivinen myelopoieesi ja neutropenia
- Vaikeat bakteeri-infektiot
- Partiaalinen okulokutaaninen albinismi (vika myös melanosyyteissä)
- Myös neurologisia muutoksia
- Tauti etenee akseleraatiovaiheeseen, kehittyy HLH (hemofagosyyttinen lymfohistiosytoosi), johon potilaat yleensä menehtyneet nuorella iällä.
Potilaskuvia koskevaa kirjallisuutta:
- Möttönen M, Lanning, M, Saarinen UM. Allogeneic bone marrow transplantation in Chediak-Higashi syndrome. Pediatr Hematol Oncol 12:55-59, 1995
- Möttönen M, Lanning M, Baumann P, Saarinen-Pihkala UM. Chediak-Higashi syndrome: four cases from Northern Finland. Acta Paediatr 92:1047-1051, 2003.
Akuutti ITP
- Yleinen lapsilla
- Perifeerisessä veressä trombosytopenia, joka joskus hyvinkin vaikea (B-Trom jopa < 5)
- Luuytimen megakaryosyyttien määrä lisääntynyt
- Megakaryosyyttien nuoruusmuotoja esiintyy, samoin pienikokoisia muotoja
- Trombopoieesin turnover lisääntynyt
- Kyseessä trombosyyttien immunologinen kato
- Muut solulinjat normaalit
Essentielli trombosytemia
- Erittäin harvinainen lapsuusiällä
- Perifeerisessä veressä huomattava trombosytoosi (>> 1000)
- Trombosyyttien tuotanto luuytimessä lisääntynyt
- Trombopoieesin morfologia normaali
- Erotusdiagnoosina polysytemia vera, jossa myös punasolujen määrä ja tuotanto on huomattavasti lisääntynyt
Kuvat: Kuvattu 04/2012 HYKS/Lastenklinikan potilaiden 30 vuoden arkistomateriaalista. Kuvia käytettäessä on lähde ja tekijät mainittava.